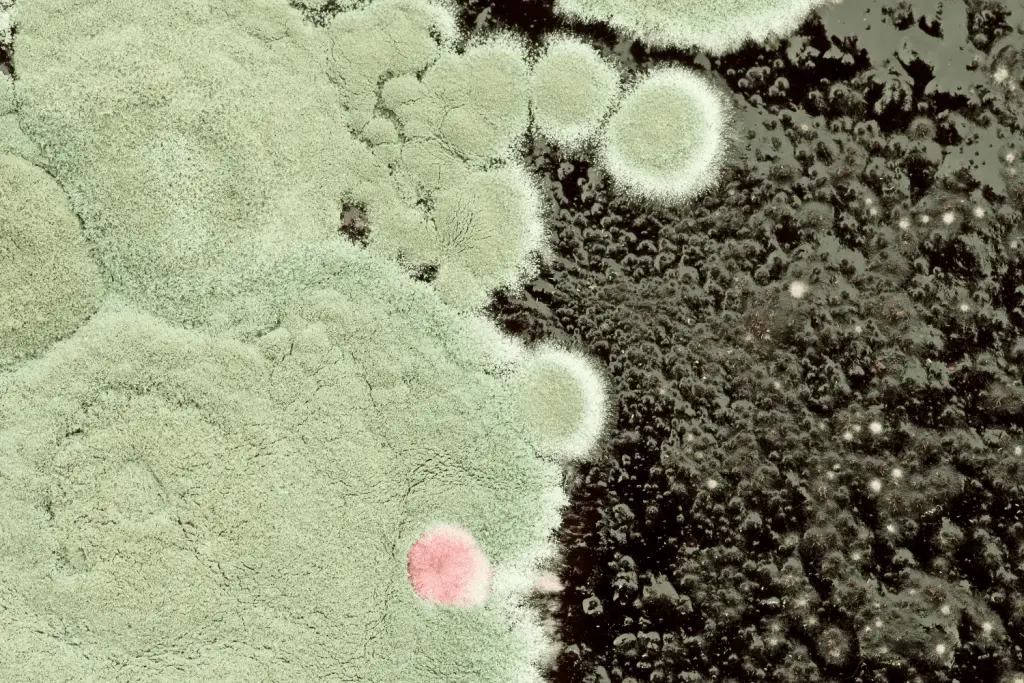
Is mold good for compost

Many people are unaware that you can compost anywhere! That rhymes but it’s true. You don’t have to have a large outdoor space to begin composting. There are now composting systems you can keep in your home or even garage and because of this there are thousands more people living a little more sustainable by composting! There is however one common question amongst beginning composters and some more experienced. That question is ” Is mold good for compost?” A knee jerk reaction might be yes is fine but after doing some research you should be a little cautious when seeing mold in your compost bins. Let’s walk through some information about composting and dive into the role of mold in composting, its functions, benefits, potential drawbacks, and how to manage its presence in your compost pile.

The composting process will turn organic matter into a nutrient-rich fertilizer. The decomposition of organic materials is driven by a big community of microorganisms, including bacteria, fungi, and other beneficial organisms. These microorganisms work synergistically to break down complex organic compounds into simpler forms, releasing valuable nutrients and creating a humus-rich substance known as compost.
The Microbial Players in Compost:
Bacteria:
Fungi:
Actinomycetes:
Protozoa and Nematodes:

The Role of Mold in Composting:
Mold, a type of fungus, is one of the key players in the decomposition process within a compost pile. Mold contributes to the breakdown of complex organic compounds, transforming them into simpler substances that are more readily available to plants. Here are the roles that mold plays in composting:
Cellulose and Lignin Decomposition:
Accelerating Decomposition:
Humus Formation:
Fungal Networks (Mycorrhizae):

Nutrient Release:
Soil Conditioning:
Disease Suppression:
Enhanced Plant Growth:

While moldy compost is generally not a huge problem in composting, certain conditions or practices may lead to concerns.
Potential drawbacks and considerations:
Excessive Moisture:
Imbalance in Materials:
Anaerobic Conditions:
Pathogenic Molds:

Optimal Moisture Levels:
Carbon-to-Nitrogen Ratio:
Adequate Aeration:
Proper Size and Location:
Monitoring Temperature:
Avoiding Diseased Plant Material:
In the world of composting, mold plays a crucial role in breaking down complex organic compounds, contributing to the creation of nutrient-rich humus that benefits plant growth.
While mold is generally a friend in composting, it’s essential to manage its presence by maintaining optimal conditions, balancing compost ingredients, and practicing proper composting techniques.

Mold spores in compost can spread through various ways, both actively and passively:
Active Spread:
Passive Spread:
Factors influencing spread:
Minimizing mold spread:
Remember, while mold is a natural part of the composting process, excessive growth can negatively impact your final product and potentially pose health risks.

Whether you can put moldy food in your compost bin depends on several factors, including the type of mold, the type of food, and your composting method.
Generally Okay:
Use Caution:
Additional Tips:
Ultimately, it’s up to you to decide whether or not to compost mold. If you’re unsure, it’s always best to err on the side of caution and throw it away. Remember, the goal of composting is to create healthy, nutritious material for your garden, so it’s not worth taking any risks.
While the color of mold can offer some clues about what types of mold they are, it’s not always a reliable indicator and shouldn’t be the sole basis for identification. Remember finding mold in your compost isn’t always bad but be cautious especially if you have an indoor compost bin.
Similar Colors, Different Molds:
Changing Colors:
Food Sources:
However, color can offer some general indications:
Therefore, it’s crucial to consider other factors for identification:

There are many different ways you can compost and it all depends on several factors, including your available space, time commitment, desired pace, and budget. Lets break down some of the different ways you can compost.
Basic Types:
Additional Options:
The best way for you to compost depends on your specific needs, space and preferences.

Green Goodies (Nitrogen-rich):
Brown Bounties (Carbon-rich):
Bonus Boosters:
Don’t put in your bin
Remember:
Now that you have learned that mold isn’t always a bad thing when it comes to composting don’t freak out if you see it. Continue caring for your compost pile or bin like usual. If you see an excessive amount of mold growing then I would step in and see what’s going on. Reassess the type of material you are adding to your bin and make sure you are turning your compost pile regularly so that it gets enough oxygen to aid in the process of decomposition.
Happy Composting!